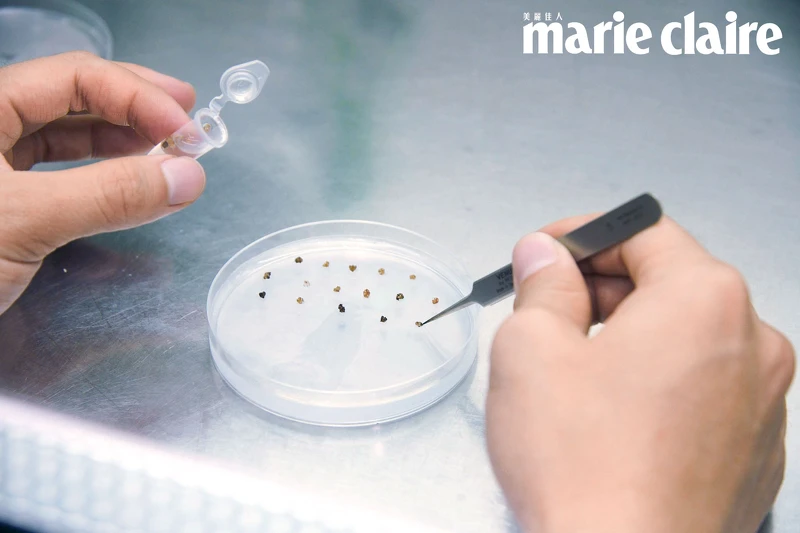
▲培育經過太空旅行的種子,可以做新的育種。 ▲培育經過太空旅行的種子,可以做新的育種。

LIFESTYLE深度聚焦
專訪|到宇宙旅行能吃什麼?打造未來生活糧食 台灣種子發射上太空
by Yves Huang-更新
採訪撰文/黃馨慧 攝影/蔡孝如

英國維珍集團創辦人布蘭森(Richard Branson)和亞馬遜創始人貝佐斯(Jeff Bezos)於2021年7月順利完成私人太空之旅後,改變了大眾的想法,當太空居住與旅行可能是未來的日常時,如何生存與自給自足,本以為遙遠的想望,已成近在眼前的議題。
為何要將種子送上太空?
日本宇宙航空研究開發機構(JAXA)有「亞洲種子上太空」的計畫,參與國將種子送往日本,日本集中送至美國發射往太空,再沿原路返回該國。國家太空中心找來全台農業領域體系最完整的中興大學參與,由農藝、園藝、檢疫等專家學者組成專案團隊,農業暨自然資源學院院長詹富智說:「台灣種子首度登上太空,除了考量未來在太空的糧食,還希望解決眼前的糧食危機。」
近年來極端氣候事件頻仍,乾旱、忽冷忽熱、暴雨淹水等影響糧食作物生產,COVID-19的疫情使得糧價、肥料價格飆漲,讓糧荒雪上加霜,根據聯合國糧農組織2021年的報告,食物不足率從8.4%上升到9.9%,全球逾七億人口挨餓。

詹富智解釋,進行糧食品種改良,增加產量、增快生長速度、抗病蟲害及適應極端氣候等,方可應付未來更嚴峻的環境,提供人類將來食物來源,改良現有品種恐需耗費十年以上光陰,已不符當前需求。將種子送上太空,在無重力又有輻射的狀態下,觀察可能對植物造成的影響,更可進一步了解能否藉由種子突變開拓種源,種子突變後的成份,未來也可能有機會廣泛運用到醫療、生醫等研究與應用面向。
另外美、日、中等國家早有嘗試將種子送上太空,再送回地球並加以研究的紀錄,國際太空站內也以「先進植物培養系統」成功收穫紅蘿蔓萵苣、蘿蔔、大白菜等,興大農藝系楊靜瑩教授表示:「太空人目前的食物單純來自地球補給以維生,若太空站內能栽種糧食,有望成為未來幫助太空人探索更遙遠星球旅程的食物。」無論近因或遠因,種子上太空都有其必要性。

開拓對環境與人體安全的新種源
送種子上太空有諸多限制,種子加上防碰撞的密封包裝,總重量不得超過50克,大部分國家會送出一至二種的特有種或大宗重要作物種子。具代表性的台灣水稻和台灣山櫻花因檢疫規定無法放行,專案團隊以重要糧食、經濟作物與本土特有種等種子進行考量,最後依種子大小、重量,選定上太空的是姬蝴蝶蘭1克、台灣藜(紅藜)10克、甜椒16克和向日葵20克。
歷經7個月的太空之旅後,種子原封不動回台,為推廣科普教育,專案團隊2022年1月舉辦教育成果展,國小學童種植未上太空的種子,比較太空人在太空站的種植情形;國高中學生則種植上過太空的種子,有發芽率和性狀等改變。楊靜瑩的實驗室內種植台灣藜種子則發現,目前上過太空的種子萌發率約八、九成,初步可判斷上太空對於種子活力影響不大,但幼苗子葉的畸形情況較多,少數甚至生長速度較快,種子經太空射線產生DNA變異,性狀當然有好有壞,可經由後續研究篩選所需的種子性狀,再培育適合未來使用的種源,日前更成功栽種已上過太空,且順利開花結穗的台灣藜,正待進一步研究。
她特別說明,種子本就會因自然環境改變而突變,為找出新種源,人工使用射線的物理性技術,或利用疊氮化鈉的化學性技術來做「誘變育種」,已是非常常見的農改技法。種子上太空後存放於太空站內,會照射到的太空射線僅是微量,且只會造成種子DNA突變,有些人會擔心這樣種出來的糧食作物跟「基改」食品一樣,楊靜瑩指出:「基改食品是運用生物技術將外來基因轉入食用作物中,比如轉入抗除草劑的基改黃豆等,被擔憂可能產生新的過敏原;使用誘變育種的種子雖然也是『基因改變』,但並非殖入外來基因,而是自體基因突變,無論種植和食用,對土地、環境甚至人體都是安全的。」

農業、食品趨勢與未來
以上太空的方式開拓新種源,是對當前與未來農業規劃版圖中的其中一塊,詹富智強調,農業早非過去刻板印象中的行業,而是導入自動化、生物科技的高科技行業,「台灣在IOT做得非常好」,為解決農業人口老化缺工,吸引年輕人加入行列,技術勢必要更精進,比如加入AI進行精準育種與栽培。
中興大學近幾年和農委會合作,成立跨農業、生技、電機、資訊等學院的智慧農業研究中心與有機農業中心,更成立植物教學醫院,診斷、鑑定、精準用藥,減少農藥與化肥使用,推廣友善有機農業,他直言:「農業未來趨勢必然朝向『精準智能、減碳永續』的目標前進。」
延伸閱讀:
